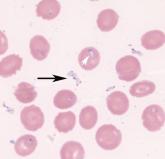

Article

Tech Tools— Innovative Devices for the ED
- Author:
- Jason Wagner, MD
The author reviews some of the most notable evolutionary and revolutionary devices and technological advancements in patient care applicable for...
Article
Severe babesiosis
- Author:
- Emmanuel King, MD
- Gerald Wertheim, MD
- Kevin Shiley, MD
- Jason Wagner, MD
- Adam Bagg, MD
- Jeff Greenblatt, MD
